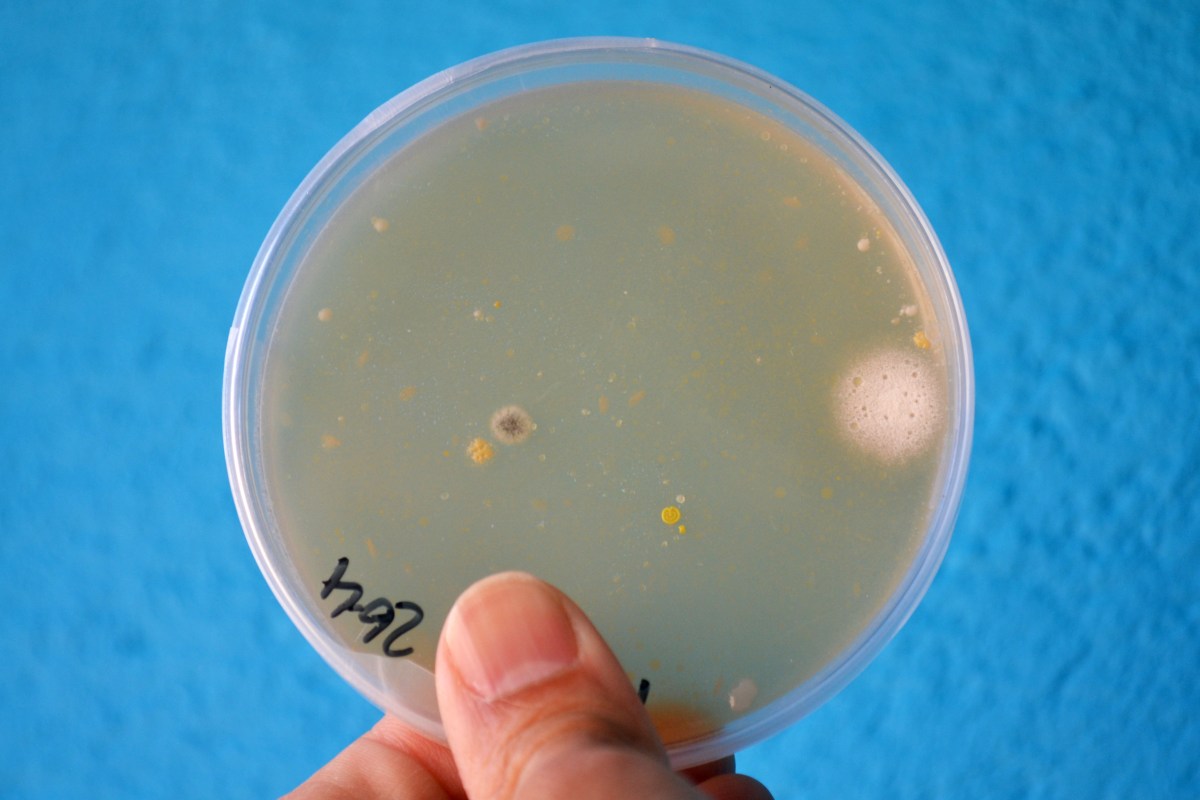
Taller de Microbiologia Extraescolars Barcelona

Archives
Model d’ADN

Vam fer el model d’ADN de l’Arvind Gupta i s’ho van passar pipa. L’Arvind parlarà a l’SteamConf, que tindrà lloc aquests dies a Barcelona. Si teniu l’oportunitat, aneu a escoltar-lo, per nosaltres és una llegenda absoluta.
Read MoreLABCLUB a La Mar Bella

Octubre i Novembre a l’Escola La Mar Bella. Ho hem passat genial amb circuits elèctrics, insectes, robotets, i fluids no-newtonians. I això és només el començament!
Read MoreCultivant els nostres bacteris!
Aquests dies hem estat fent alguns experiments senzills de microbiologia. El procediment és ben fàcil: cada nen o nena deixa la marca dels seus dits en una placa de Petri, tapem la placa i només cal esperar uns dies a veure si…
Read MoreTaller de Biologia Cel·lular: Cèl·lules Vegetals

Com a primera aproximació a la biologia cel·lular i la microscòpia, vam preparar cèl·lules de ceba amb tinció de blau de metilè. Un experiment clàssic per conèixer l’estructura de les cèl·lules vegetals. Per acabar d’entendre els detalls, vam poder jugar…
Read MoreTaller de Zoologia

Després del taller del passat mes d’octubre, vam tornar amb més zoologia a l’Escola de la Concepció. Vam conèixer de prop la morfologia, costums i diferents tipus de metamorfosi dels insectes observant alguns grills i escarabats de la farina, encara…
Read MoreEls insectes bastó

Comencem setembre amb nous fitxatges a LABCLUB: els insectes bastó (Carausius morosus), uns experts del camuflatge. Amb ells prepararem noves activitats per aprendre un munt de coses sobre la vida dels insectes.
Read MoreMini-hivernacle CD

No teniu espai a casa per muntar un hort? Cap problema, podeu fer un mini-hivernacle amb una capsa de CD.
Read MorePrimer Taller de Biologia Cel·lular

Biologia Cel·lular per als més petits (4-7 anys) Cell Biology for Kids (aged 4-7) Biología Celular para los más pequeños (4-7 años)
Read More LAB CLUB
LAB CLUB
